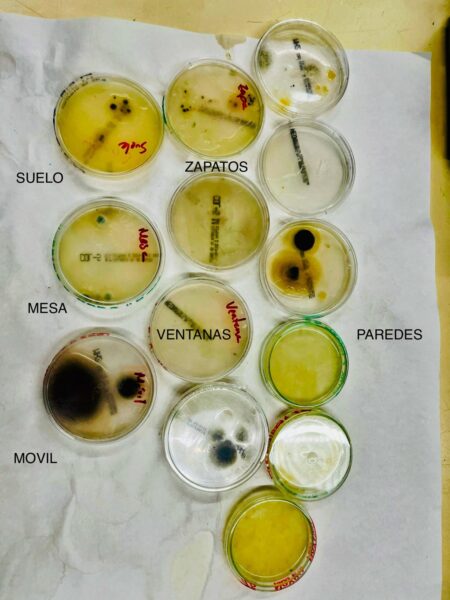

Skip to content
CIENTÍFICAMENTE DEMOSTRADO: EL MOVIL TIENE VIDA PROPIA
Los alumnos de 1 de la ESO han demostrado que en la pantalla del móvil hay microorganismos .
Para ello han hecho primero un cultivo en placas Petri y después de tener las manos limpias han tocado diferentes superficies, entre ellas su propio móvil. Como se puede observar en la imagen el crecimiento de microorganismos es muy grande en la placa del móvil.
¡¡ESTO ES CIENCIA!!
Comparte esta información en tu red social favorita